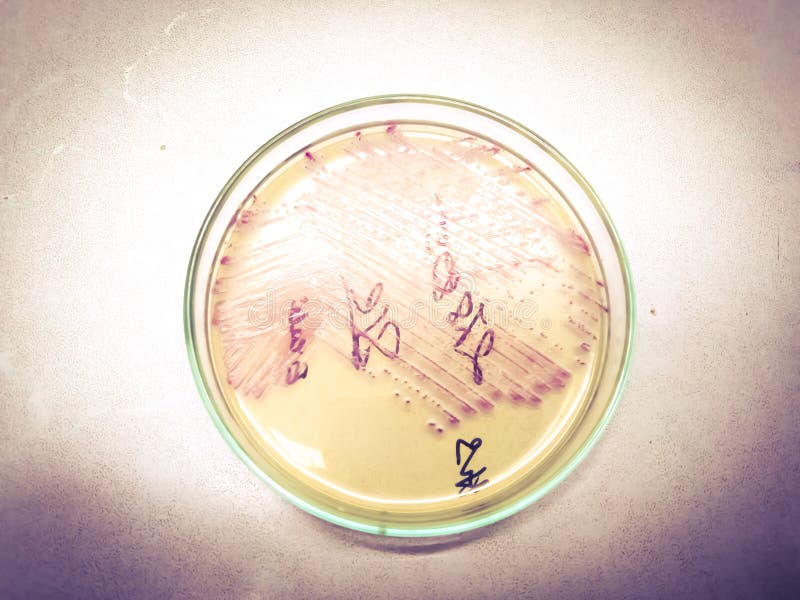
9 3 Media Used For Bacterial Growth Microbiology Canadian Edition 9 3 Media Used For Bacterial Growth Microbiology Canadian Edition

Macorecnomies Growth Components: A Beginner’s Guide
Macorecnomies Growth Components are a framework for understanding the levers that drive expansion in modern products. This beginner’s guide to Macorecnomies Growth Components breaks down the core ideas, practical steps, and common pitfalls so you can start applying them to your project today.
Key Points
- Understanding the core growth loop helps you identify where momentum originates in Macorecnomies Growth Components.
- Activation and onboarding quality can significantly impact long-term retention and revenue within Macorecnomies Growth Components.
- Quantitative metrics should be aligned with qualitative signals to reveal true performance across the components.
- Iterative experiments are essential to validate hypotheses about Macorecnomies Growth Components using a simple test plan.
- Clarity about the target audience and value proposition strengthens the overall effectiveness of Macorecnomies Growth Components.
What are the Macorecnomies Growth Components?
Macorecnomies Growth Components describe the key levers that influence user acquisition, engagement, and monetization. In practice, they map to stages such as attracting visitors, converting them to active users, retaining them over time, generating revenue, and encouraging sharing or referrals. When you view a product through this lens, you can prioritize changes that have the biggest impact on growth rather than chasing vanity metrics.
Core ideas and how they fit together
Acquisition is how you bring people to your product. It includes search, social, partnerships, and word of mouth. Activation focuses on a smooth first experience that convinces users they have found value. Retention and Revenue follow, with Retention measuring recurring use and Revenue capturing sustainable monetization. Finally, Referral drives new arrivals by encouraging satisfied users to share.
Applying the framework: a beginner-friendly approach
Start with a simple growth hypothesis based on your product’s value, then run small, controlled experiments to test it. Track a handful of core metrics (e.g., new signups, activation rate, 7-day retention, ARPU, and referral rate) and iterate based on results.
Step 1: Define a precise hypothesis about one growth component. Step 2: Create a small experiment with a measurable outcome. Step 3: Run the test for a fixed period and compare results to the baseline. Step 4: Decide on next actions based on whether results were positive or negative.
With practice, Macorecnomies Growth Components become a repeatable framework for evaluating product changes and prioritizing work. Keep the scope small and the data clean as you build intuition.
What exactly are Macorecnomies Growth Components?
+Macorecnomies Growth Components are the essential levers that influence how a product attracts users, engages them, and sustains revenue over time. They typically map to Acquisition, Activation, Retention, Revenue, and Referral, forming a growth loop that organizations can measure, experiment with, and optimize.
How do I start measuring these components?
+Begin with a lightweight dashboard focused on key signals: new users, activation rate, short-term retention, average revenue per user, and referral rate. Track trends over time and run controlled experiments to see which changes move the needle.
Can beginners apply these concepts to any product?
+Yes. The framework is adaptable across product types—from SaaS to consumer apps to services. The specifics of metrics and experiments will vary, but the underlying loop remains the same: acquire, activate, retain, monetize, and refer.
What mistakes should I avoid when analyzing growth components?
+Avoid chasing vanity metrics, neglecting data quality, or skipping controlled experiments. Focus on hypotheses with clear outcomes and measure them against a reliable baseline to drive meaningful improvements.